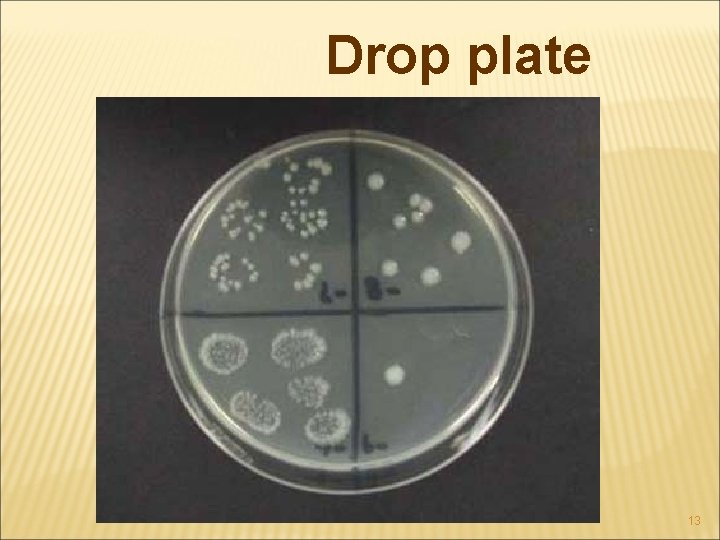
Drop plate 13

METHOD FOR THE MICROBIOLOGICAL EXAMINATION OF FOODS 1205

METHOD FOR THE MICROBIOLOGICAL EXAMINATION OF FOODS 1205 324 Food Industrial Microbiology 1

METHOD Traditional method • • • Plate counts Membrane filtration Most probable number Direct microscopic count Dye reduction tests Indicator Rapid Method Direct epifluorescent filter technique (DEFT) Electrical impedance Enzyme-linked immunosorbent assay(ELISA) 2

Plate count method Standard plate count (SPC) Aerobic plate count (APC) Total bacteria count (TBC) Total viable count (TVC) “Live” 3

Plate count method • Diluent • 0. 85%Na. Cl • 0. 1% peptone • Phosphate buffer • Medium • Pour plate • Spread plate • Drop plate • Elective medium • Selective medium • General • Petri dish plate • Replication 4

PLATE COUNT DEPENDS ON � Diluent � Food homogenate � Dilution series � Medium � Plating method � Incubate conditions 5

BAIRD-PARKER AGAR Selective agent Sodium tellulite Lithium chloride Staphylococcus aureus Elective agent Sodium pyruvate Glycine Diagnostic agent Egg yolk ne o z e u Opaq 6

Plate count method 7

Pour plate 8

Spread plate Number of colony forming units (cfus) ? ? ? 9

Spread plate Number of colony forming units (cfus) ? ? ? 10

DISADVANTAGE OF PLATE COUNT ? ? ? ? ? 11

Drop plate • Sample: • Small vol. ≈ 20 μL • Cost 12
Drop plate 13

APPLICATION OF PLATE COUNT �Check quality of RM & final products �Check condition hygiene �Estimate storage life of products �Determine �Production �Transport �Storage �Determine pathogens 14

SELECTION OF MEDIA IN FOOD MICROBIOLOGY Medium Use Plate count agar Aerobic mesophilic count Mac. Conkey broth MPN of coliforms in water Brilliant green/Lactose/Bile broth MPN of coliforms in food Braid Parker agar Staphylococcus aureus Thiosulfate/Bile/Citrate/agar Vibrio sp. Adam and Moss (2003) 15

STREAK TECHNIQUE http: //www. towson. edu/~cberkowe/medmicro/images/streak. gif 16

Filtration 0. 45 μm Liquid food • Low number of MO. Large volume of food • Count • Sterilize http: //www. biology. lsu. edu/webfac/rgayda/biol 1011/Lecture_notes. F 2004/lecture 8. pdf 17

MOST PROBABLE NUMBER Most probable number (MPN) Multiple tube techniques • Pathogen § Number too low • • Coliform Escherichia coli Staphylococcus aureus Feacal streptococci 18

MOST PROBABLE NUMBER Medium Organisms assessed Lauryl sulfate tryptose broth Coliforms Mac. Conkey purple broth Coliforms EC broth Faecal coliform Glucose azide Faecal streptococci Minerals modified glutamate medium Coliforms Baird-Parker broth Staphylococcus aureus 19

MICROSCOPIC COUNT Direct microscopic count (DMCs) Small sample (0. 01 ml) & rapid Optical light microscope Total cell Ex. • Milk living & dead cells • Wine Foods • Yogurt starter Liquid • Tomato sauce Semi-solid • Howard mold 20

MICROSCOPIC COUNT 21

COMPARISON OF SENSITIVITY OF METHOD Method Vol. of sample Count (cfu/g) (ml) Direct microscopy 5 x 10 -6 2 x 106 Drop plate (Miles and Misra) 0. 02 5 x 102 Spread plate 0. 1 102 Pour plate 1 10 MPN 3 x 10 +3 x 1 + 3 x 0. 1 0. 36 22

DYE-REDUCTION TEST Methylene blue Resazurin (blue) Leuco-methylene blue Resorufin (pink) Triphenyltetrazolium chloride (leuco) Dihydroresofin (leuco) Formazan (red) 23

INDICATORS • Hygiene indicator • Cross contamination • Fresh meat • Raw milk • Pasteurized milk 24

ATP PHOTOMETRY ATP : Adenosine triphosphate Synthesis of new cell Active transport (uptake of materials from environment) Movement Light production 25

ATP PHOTOMETRY Luciferin + luciferase + ATP + O 2 Mg 2+ Oxyluciferin + luciferase + AMP + light 1 ATP photon light 1 26

ATP PHOTOMETRY Bacteria cell 1 fg of ATP Yeast cell 100 fg of ATP • Limit of ATP photometry 102 -103 fg ATP/ml fg = femto gram = 10 -15 g 27

ATP PHOTOMETRY Break down the non-microbial cells in food Remove non-microbial ATP using ATPase Release ATP from bacteria cell Addition of luciferin & luciferasee Record light emission (ATP photometry) 28

ATP PHOTOMETRY Application Fresh meat Milk Starter culture Test UHT milk Surface contamination 29

ATP PHOTOMETRY Disadvantage Mixed bacteria & yeast cell Dilution Remove cell before ATP measured Filtration Centrifugation 30

DIRECT EPIFLUORESCENT FILTER TECHNIQUE (DEFT) Liquid food Filter through membrane Acridine orange : fluorescent dye (fluorochrome) pour through filter Epifluorescent microscopy Count: manual or automatic • Direct microscopy • Membrane filtration • Vol. of sample • Filter area • Area of microscope field • Number of field 31

DIRECT EPIFLUORESCENT FILTER TECHNIQUE (DEFT) Acridine orange bineds to: RNA --- fluorescent orange DNA --- fluorescent green Viable cell RNA DNA RNA > DNA --- orange Non-viable cell DNA > RNA ---green 32

DIRECT EPIFLUORESCENT FILTER TECHNIQUE (DEFT) Viable Non-viable 33

Membrane epiflurescent www. teagasc. ie/research/reports/foodprocessi A rapid technique for the detection of pathogens in food products 34

Membrane epiflurescent 35

Impedance : resistance Bacteria growth ----decrease impedance ----increase conductivity Conductance ELECTRICAL IMPEDANCE METHOD Time DT Detection time 106 -107 cells/ml 36

ELECTRICAL IMPEDANCE METHOD Bactometer Vary temp Small volume Many wells Many samples • Count • Growth Automatic 37

Bactometer 38

ELISA Antigen – conjugate enzyme Antibody – conjugate enzyme Pathogen • Salmonella • Listeria • S. aureus Toxin • Staphylocaccal • Botulinum toxin • Mycotoxin 39

ENZYME-LINKED IMMUNOSORBENT ASSAY Free toxin Antibody Antigen(toxin) Labeled toxin Enzyme Microtitration plate Alkaline phosphatase (ALP) Horse Radish Peroxidase (HRP) Substrate Tetramethylbenzidine (TMB) + 30% H 2 O 2 Azinobis sulphonic acid (ABTS) o-phenylinediamine (OPD) p-nitrophenyl phosphate 40

41

“ELISA” 42

SANDWICH-ELISA E. coli Salmonella Colorless Substrate Antibody-conjugate enzyme antibody Color 43

Aflatoxin flavus A. nomius A. tamarri A. parasiticus “Aflatoxin” Aspergillus toxin 44

45 http: //msa. ars. usda. gov/la/srrc/aflatoxin/afcrsp. htm

ENZYME-LINKED IMMUNOSORBENT ASSAY Free toxin Antibody Antigen(toxin) Labeled toxin Enzyme Microtitration plate Alkaline phosphatase (ALP) Horse Radish Peroxidase (HRP) Substrate Tetramethylbenzidine (TMB) + 30% H 2 O 2 Azinobis sulphonic acid (ABTS) o-phenylinediamine (OPD) p-nitrophenyl phosphate 46

Aflatoxin: Colorless E E Coloration 47

“ELISA” Antibody Aflatoxin (free toxin) E Aflatoxin-enzyme labeled (labeled toxin) Substrate 48

Direct Competitive ELISA Conc. (ppb) 0 5 10 15 20 Aflatoxin E E 49

Direct Competitive ELISA ppb 0 5 10 Standard (Aflatoxin) 15 A B C Foods ample (Un-know) A= ? ? ? ppb B= ? ? ? C= ? ? ? ppb 50

ELISA Qualitative result Quantitative result color Absorbant Micro ELISA reader Spectrophotometer Standard curve Concentration 51

PCR 52 home. nvg. org/~forthun/ cdr-lenker. html

53

THE END 54
- Slides: 54